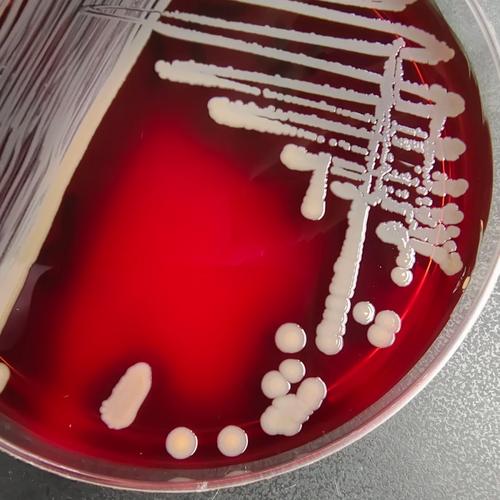
新生儿金色葡萄菌感染-第3张图片-郑州医学网

什么是金黄色葡萄球菌?
金黄色葡萄球菌是一种常见的革兰氏阳性球菌,广泛存在于自然界、人的皮肤、鼻腔和咽喉中,对于健康成人,它通常不致病或只引起轻微皮肤感染,但对于新生儿,它可能成为“机会致病菌”,引发严重感染。

其特点:
- 传染性强:可以通过接触(如医护人员、家长的手)、飞沫或污染的物品(如衣物、奶具、医疗设备)传播。
- 耐药性:部分菌株(如MRSA,耐甲氧西林金黄色葡萄球菌)对多种抗生素耐药,增加了治疗难度。
新生儿感染金葡菌的途径
- 产时感染:分娩过程中,胎儿通过被金葡菌污染的产道时吸入或吞入细菌。
- 产后感染(最常见):
- 接触传播:医护人员或家长的手是主要传播媒介,如果手部卫生不到位,很容易将细菌传给新生儿。
- 环境物品:被污染的婴儿床、衣物、毛巾、尿布、玩具、奶瓶等。
- 母亲感染:母亲患有乳腺炎、皮肤感染或鼻部带菌,可通过哺乳或密切接触传染给新生儿。
- 医疗相关:在新生儿重症监护室,由于需要侵入性操作(如插管、吸痰),感染风险更高。
新生儿金葡菌感染的主要类型和症状
感染可发生在身体的任何部位,症状轻重不一。
皮肤和软组织感染(最常见)
- 脓疱疮:
- 症状:皮肤上出现快速增多的、周围有红晕的水疱或脓疱,疱液呈淡黄色,容易破裂,露出鲜红色湿润的糜烂面,结蜜黄色痂,常见于面部、四肢和尿布区域。
- 特点:传染性极强,可迅速扩散。
- 新生儿脓疱疹:
- 症状:一种严重的脓疱疮,范围更广,常伴有发热、精神萎靡、吃奶差等全身症状,可能导致皮肤大片剥脱,类似烫伤。
- 脐炎:
- 症状:脐带根部红肿、有分泌物(可为脓性),伴有臭味,严重时可导致败血症。
- 疖、痈:
- 症状:皮肤上出现红色、疼痛的硬结,中央可能变软、化脓,形成脓头。
肺部感染(金葡菌肺炎)
- 症状:
- 呼吸急促、困难:呼吸频率明显增快,鼻翼煽动,呻吟。
- 呻吟:是新生儿肺炎的一个重要信号,表明呼吸困难。
- 口唇发绀:嘴唇、指甲床发紫,提示缺氧。
- 反应差、拒奶:精神萎靡,不爱吃奶。
- 发热或体温不升:体温可能升高,也可能低于正常。
- 咳嗽:咳嗽可能不明显,但可听到肺部有痰鸣音或湿啰音。
败血症和脓毒症(最严重,可危及生命)
细菌进入血液,引起全身性炎症反应。
- 症状:
- 全身反应差:精神萎靡、嗜睡、面色苍白或发灰、反应迟钝。
- 体温不稳定:发热或体温不升。
- 吃奶困难:拒吸、吸吮无力、吃奶量减少。
- 心率快或慢:心跳异常增快或减慢。
- 黄疸加重或消退延迟:生理性黄疸可能突然加重或迟迟不退。
- 肝脾肿大:医生体检时可发现肝脏或脾脏变大。
- 休克前期表现:皮肤出现花纹、四肢发凉、毛细血管再充盈时间延长(按压皮肤褪色后恢复时间超过2秒)。
其他感染
- 脑膜炎:可出现前囟门饱满、张力增高、嗜睡、抽搐、呕吐等症状。
- 骨髓炎/化脓性关节炎:表现为肢体活动受限、局部红肿、拒绝触碰。
- 中耳炎:表现为烦躁不安、抓挠耳朵。
如何诊断?
医生会根据新生儿的临床表现,结合以下检查进行诊断:

- 血常规:白细胞计数和中性粒细胞比例通常显著升高,但严重感染时也可能降低。
- C反应蛋白 和降钙素原:这两个是炎症指标,显著升高提示严重细菌感染。
- 病原学检查(确诊的关键):
- 血培养:诊断败血症的“金标准”。
- 脓液/分泌物培养:从脓疱、脐部分泌物等部位取样,进行细菌培养和药敏试验,以明确是金葡菌并指导用药。
- 痰培养:怀疑肺炎时进行。
- 脑脊液检查:怀疑脑膜炎时进行。
如何治疗?
治疗原则:早期、足量、足疗程,并根据药敏结果选择敏感抗生素。
-
抗生素治疗:
- 经验性治疗:在等待药敏结果前,医生会根据当地耐药情况选择可能有效的抗生素,如苯唑西林、头孢类抗生素等。
- 目标性治疗:一旦药敏结果出来,会立即调整为最敏感的抗生素。
- 严重感染(如败血症、肺炎):需要静脉输液给药,疗程通常需要2周或更长。
- 轻症皮肤感染:可局部涂抹抗生素药膏(如莫匹罗星软膏)。
-
局部处理:
- 脓疱疮:可用无菌针头挑破水疱,用生理盐水或消毒液清洁,然后涂抹药膏。
- 脐炎:用75%酒精或碘伏每日清洁消毒2-3次,保持干燥。
-
支持治疗:
(图片来源网络,侵删)
(图片来源网络,侵删)- 保证充足的营养和液体摄入。
- 对于呼吸困难的新生儿,可能需要吸氧甚至呼吸机支持。
- 纠正电解质紊乱和休克。
如何预防?(非常重要!)
预防是关键,主要措施在于切断传播途径。
-
严格的手卫生:
- 这是最重要的一点! 接触新生儿前,家长和访客都必须用肥皂和流动水彻底洗手,或使用含酒精的免洗洗手液。
- 医护人员在接触每个新生儿前后也必须严格执行手卫生。
-
做好个人和环境清洁:
- 保持新生儿皮肤清洁干燥,尤其是皮肤褶皱处和臀部。
- 勤换尿布,保持臀部干爽,预防尿布疹。
- 每日清洁和消毒婴儿床、玩具等物品。
- 新生儿的衣物、毛巾、被褥要专用,并勤洗勤晒。
-
脐部护理:
- 保持脐带残端清洁干燥,每日用75%酒精消毒根部,直至其自然脱落,避免包裹过紧,保持透气。
- 脐带脱落后,也要注意观察有无红肿、分泌物。
-
隔离感染源:
- 如果家庭成员(尤其是母亲)有皮肤感染、感冒或腹泻,应避免接触新生儿,必须接触时要戴口罩并严格洗手。
- 母亲患乳腺炎时,应遵医嘱决定是否暂停哺乳。
-
合理使用抗生素:
避免滥用抗生素,这会筛选出耐药菌株。
新生儿金葡菌感染是一个不容忽视的问题,家长需要了解其常见症状,特别是精神状态差、吃奶不好、呼吸异常、皮肤出现脓疱等危险信号,一旦发现应立即就医,通过严格的手卫生和良好的个人卫生习惯,可以有效预防感染的发生,早发现、早诊断、早治疗是改善预后的关键。
标签: 新生儿金色葡萄球菌感染症状 新生儿金色葡萄球菌感染治疗 新生儿金色葡萄球菌感染预防






